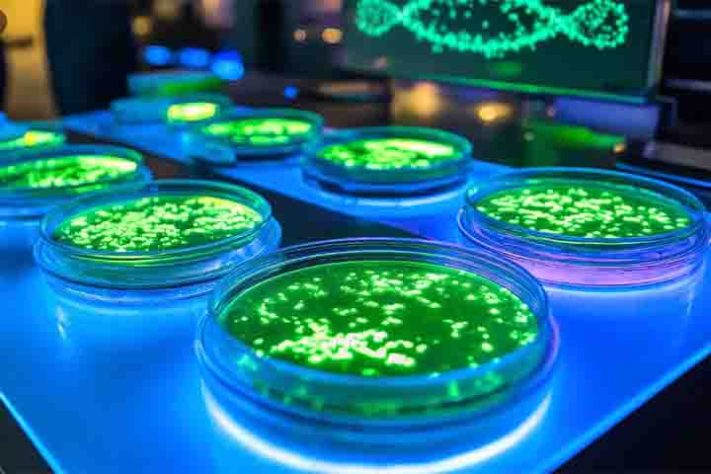

Toxinas em folhas comestíveis: o que são nanoplásticos e o risco para a saúde
Toxinas em folhas comestíveis: o que são nanoplásticos e o risco para a saúde
https://www.flipar.com.br/wp-content/uploads/2026/03/Nanoplastico.jpg
2026-03-27T12:00:17-03:00
2026-03-27T01:44:59-03:00